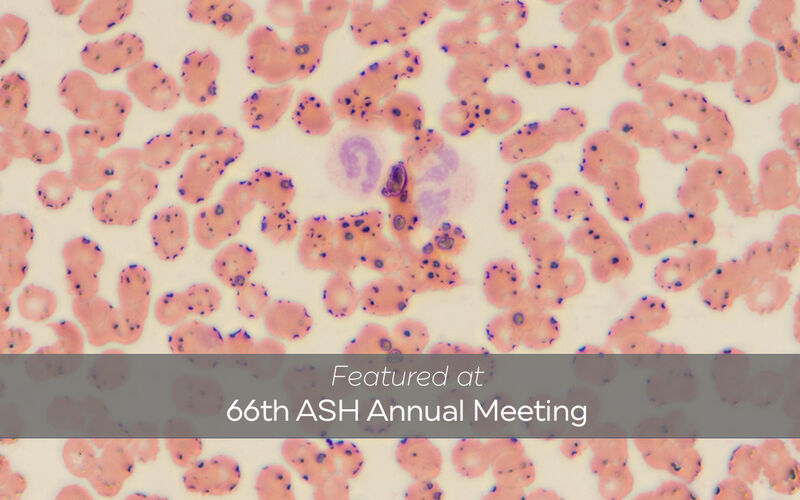
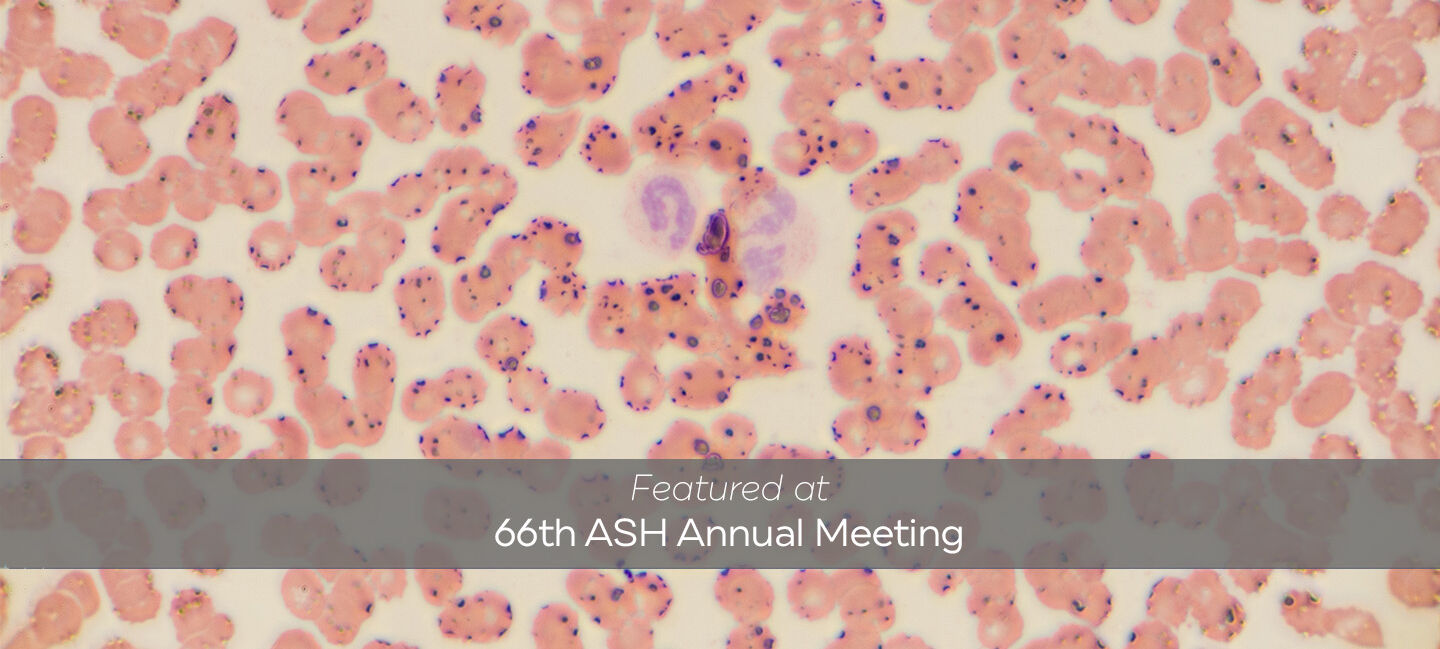

Study Reveals Key Insights Between New Blood Condition and Lower-Risk Myelodysplastic Syndromes
Clonal cytopenia of undetermined significance (CCUS) is a newly identified condition that falls between normal bone marrow function and a more severe condition called lower-risk myelodysplastic syndromes (MDS).
While both CCUS and lower-risk MDS share similar characteristics like low blood cell counts and genetic mutations in blood cells, CCUS lacks the distinct structural abnormalities in any bone marrow lineage seen under a microscope that define lower-risk MDS.
There are still some important questions in diagnosing and managing CCUS, including how to tell it apart from lower-risk MDS and when and how to treat patients with CCUS.
A new study led by Zhuoer Xie, MD, from Moffitt Cancer Center's Malignant Hematology Department provides insights into these two conditions and underscores the value of refining our understanding of their overlapping characteristics.
The goal of the research was to compare CCUS and lower-risk MDS by looking at their clinical features and outcomes, such as survival rates. The study used modern risk models and data from two groups: one from the National MDS Natural History Study and another from Moffitt.
The study included over 600 patients with CCUS or lower-risk MDS, with every diagnosis carefully reviewed by expert pathologists to ensure accuracy.

Zhuoer Xie, MD
To better understand the risk of disease progression, researchers applied two advanced tools: the clonal hematopoiesis risk score and the clonal cytopenia risk score. These scoring systems assess factors such as genetic mutations, blood test results and patient demographics, helping to classify CCUS patients into low, intermediate and high-risk categories.
The results presented at the American Society of Hematology annual meeting revealed that high-risk CCUS patients by clonal hematopoiesis risk score and clonal cytopenia risk score tools have similar characteristics and outcomes to patients with lower-risk MDS.
There were no major differences in factors like age or gender between the two groups. Both groups had similar levels of low blood cell counts. High-risk CCUS patients had similar survival rates and disease progression patterns to lower-risk MDS patients, suggesting there is no discernable clinical overlap between high-risk CCUS and low-risk MDS and supporting that clinical decision-making should be tailored to risk categories.
“The data confirmed that the clonal hematopoiesis risk score and clonal cytopenia risk score are effective tools for predicting CCUS risks," Xie said. "This helps doctors assess CCUS more accurately and use a more tailored approach to patient care. For instance, high-risk CCUS patients might benefit from treatments similar to those used for lower-risk MDS, while low-risk patients could avoid unnecessary treatments.”
By comparing CCUS and lower-risk MDS, researchers aim to enhance patient care in several ways. First, understanding the nature of CCUS allows doctors to avoid unnecessary treatments for low-risk patients, sparing them from potential side effects and reducing the burden of care.
Second, identifying high-risk CCUS patients enables closer monitoring and more proactive management, potentially preventing disease progression.
Lastly, given the clinical similarities, high-risk CCUS merits inclusion in lower-risk MDS clinical trials, ensuring access to potential therapy that improves quality of life and mortality.
The findings pave the way for personalized patient care, offering hope for improved outcomes for patients facing these complex conditions.